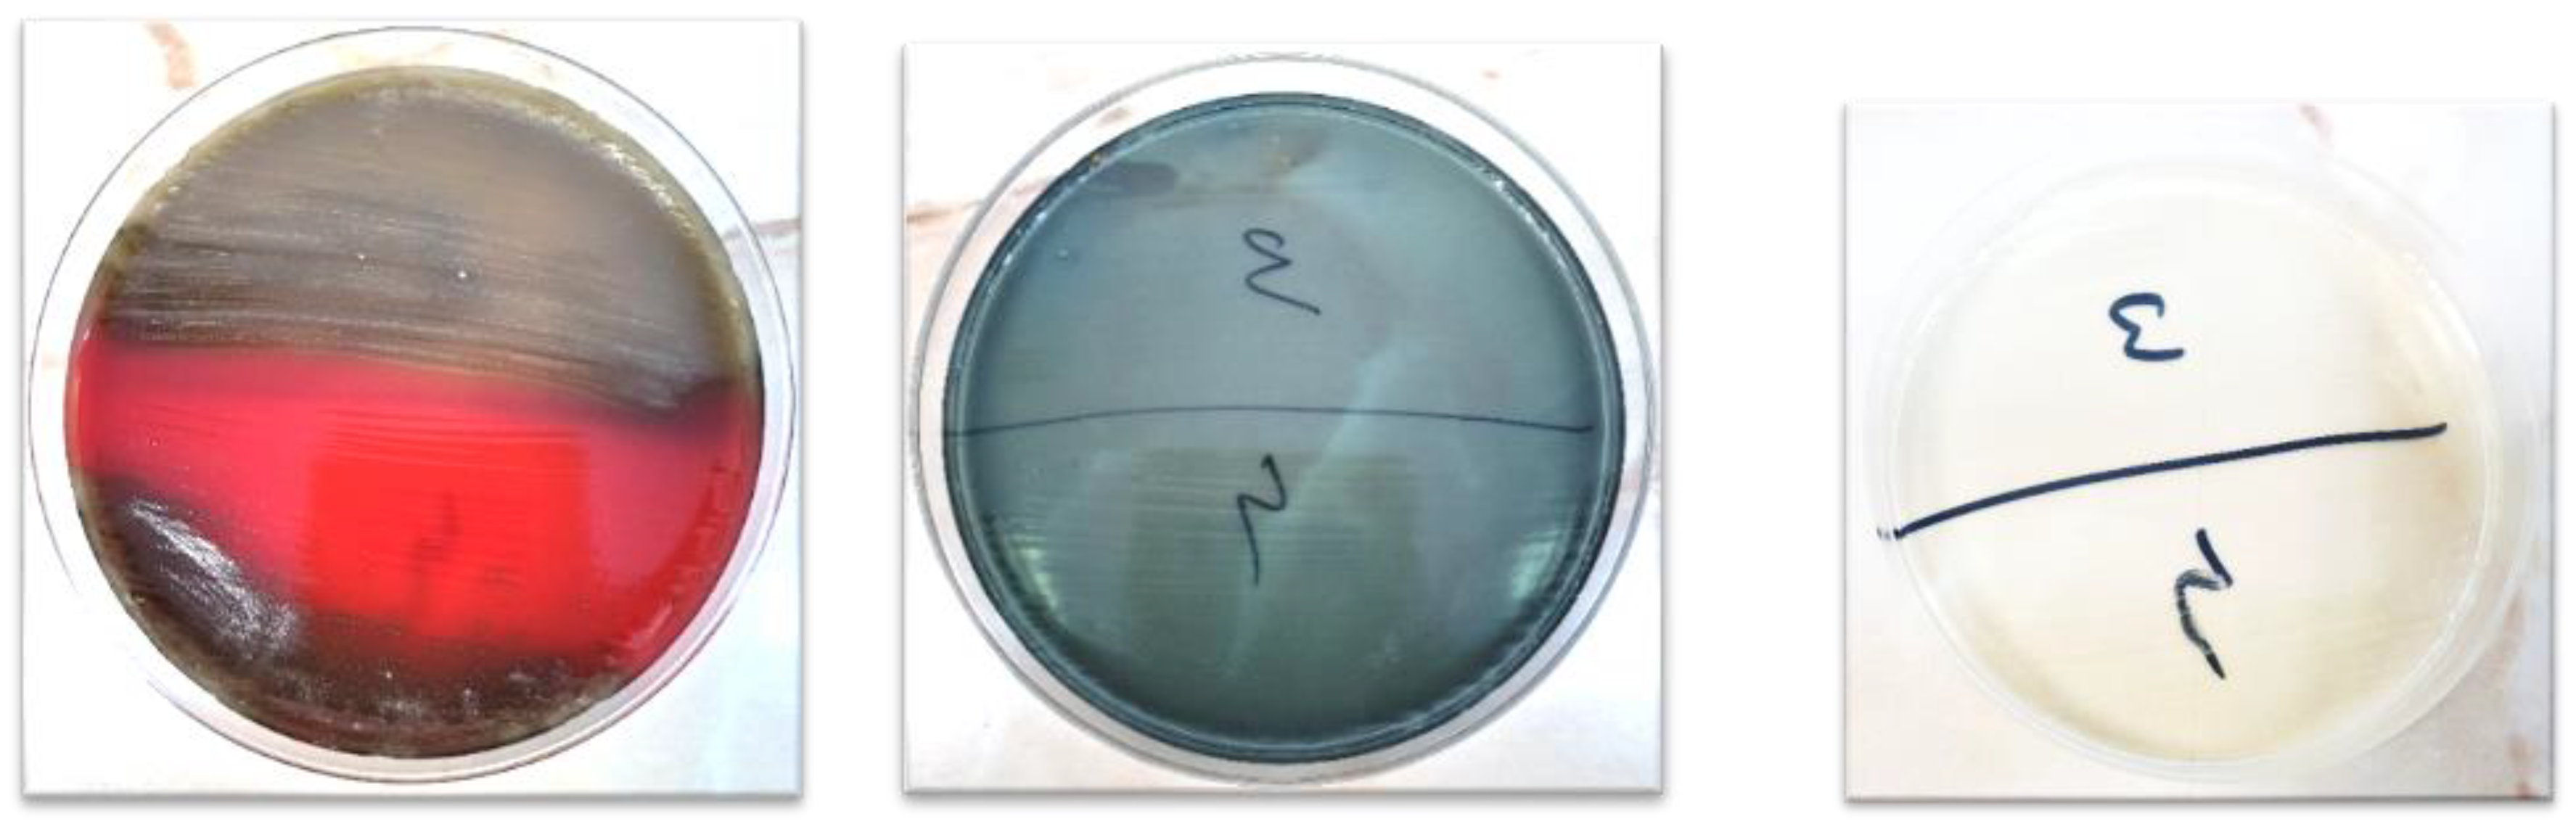
Germs 14 00028 g003

Abstract
Introduction: Assessment of the denture plaque can provide a valuable report regarding the oral health of geriatric patients and the oral hygiene habits in this population group. Focusing on the current research gap on this topic in Romania, our research aims to highlight the microbial plaque on the different surfaces and types of removable poly(methyl methacrylate) (PMMA) prostheses to qualitatively evaluate the microbial species, and to assess the combined effect of mechanical and chemical cleaning of dentures on the prosthetic microbiome. Methods: The prosthetic plaque from four denture wearers was identified with a UV activated fluorescent revealer and digitally photographed. Swab samples according to a certain hygiene protocol were cultured on three different growth media such as blood agar (BA), bromothymol blue lactose agar (AABTL) and Sabouraud dextrose agar (SDA). Results: Denture plaque was variably distributed on the surface of the prostheses. Regardless of the denture type (conventional complete denture, tooth or implant supported overdenture, removable partial denture) the microbial plaque was identified at the retentive areas, especially at interdental spaces. The main plaque deposition areas were the vestibular incline of the labial flange of the maxillary denture and the lingual incline of the posterior lingual flange of the mandibular denture. The prosthetic microbiome consisted of pathogenic Gram-positive aerobes (Streptococcus spp. and coagulase-negative Staphylococcus spp.), Gram-positive anaerobes (Actinomyces spp. and Klebsiella spp.) as well as subspecies of fungi of the genus Candida. Conclusions: Despite its poor variety, the denture microbiome in the investigated cases hosts colonies with high pathogenic potential. Some areas of the prostheses are more likely to accumulate dental plaque. Dentists should insist through more regular checks of the patients and their caregivers on ensuring the biocontrol of the dentures, especially in frail geriatric patients exposed to greater risks related to general health.
Introduction
Among the several oral diseases and disease burden for oral health” [1]. The incidence of complete edentulism in Romania in 2003 was disabilities the elderly suffer from, the complete loss of teeth is considered as the “final marker of estimated at 26% by the World Health Organization (WHO) [2], recording a significant decrease of up to 14.2% [3]. at the date of the latest WHO report, in 2019. Despite the contemporary therapeutic progress for complete edentulism covered by implants, conventional removable poly(methyl methacrylate) (PMMA) dentures remain the most common prosthetic restoration for this severe disability in Romania, as a consequence of the general condition of the elderly [4]. and of financial constraints [5]. Moreover, economic limits influence their prolonged wearing period without reconditioning. As a result, old unstable dentures promote accelerated ridge resorption [6], mucosal irritation, denture stomatitis [7], aliments accumulation under the dentures, severe masticatory and nutritional dysfunctions [8], the increase of microorganisms’ adhesion, both on biotic and abiotic surfaces [9], and also aspiration pneumonia due to high denture plaque reservoirs, especially among seniors with poor oral and denture hygiene [10,11,12].
The attempt to minimize the inconveniences caused by old and even new prostheses resulted in new techniques and materials that have revolutionized this field of prosthodontics in the last two decades. Thus, the concept of the twoimplant-supported mandibular overdenture as the basis of the McGill and York consensus from 2002 [13]. and respectively 2009 [8]. was a worldwide success with a significant increase in oral healthrelated quality of life (OHRQoL) of denture wearers [14]. Furthermore, the denture base material that dominated the removable prosthodontics was represented by polymers [15], followed by polycarbonate (PC), polyurethane (PU), polyamide (PA), polyoxymethylene (POM), and polyaryletherketone (PAEK) [16]. The leadership of PMMA is attributed to its simplicity of processing, light weight, superior biocompatibility, low cost, aesthetic properties and stability in the oral environment [17,18]. However, it also suffers from shortcomings, among which its water sorption capacity [19]. is of major concern, facilitating bacterial colonization [20,21]. while wearing PMMA dentures.
Although the microbiology of denture plaque received fewer debates compared to dental plaque until now [22], scientific reports underline the prosthesis plaque as a predictor of the general state of health among the elderly [23]. In fact, denture plaque is strongly increased among the elderly by the decrease in oral hygiene due to vision disorders [24], lower tactile thresholds and dexterity [25,26], and decrease in cognitive function [27]. Both removable dentures and implant restorations or attachments present challenges with regard to handling and cleaning, hence, the main purposes of our research were to qualitatively assess the denture microbiome and to map the areas on the PMMA dentures more prone to accumulate significant amounts of microbial plaque. The hypothesis was that the prosthetic microbiome exhibits a varied microbial composition, which disappears completely after establishing a daily hygiene protocol consisting of both mechanical and chemical cleansing methods, by testing the four most popular denture cleansers available in the market for hygiene products for prostheses in Romania.
Methods
The case study series included four acrylic denture wearers (aged between 70 and 79 years) among the patients who consecutively applied to the Discipline of Prosthodontics of the Faculty of Dentistry of the University of Medicine and Pharmacy “Carol Davila” in Bucharest at the beginning of the academic year 2022-2023. The research was approved by the Scientific Research Ethics Committee of “Carol Davila'' University of Medicine and Pharmacy, Bucharest, Romania (Protocol number: 36366/29.11.2023). A written informed consent was expressed by the participants, in which the duration, purpose, research manner and dissemination of the results through publication were clarified in detail. The eligible candidates were the wearers of a PMMA removable denture (conventional, teeth supported overdenture or implant supported overdenture) at least for the upper jaw, for a minimum duration of six months, and with complete medical records.
The study was carried in two stages. Initially, the subjects were instructed to follow the habitual oral and denture hygiene, without instructions from the examiners. In the second stage the protocol indicated the mechanical hygiene twice daily (brushing of oral structures with toothpaste/ brushing of dentures with unspecific liquid soap) and the chemical hygiene of the dentures by using specific disinfecting tablets. Commercial products, Blend-a-Dent (Procter & Gamble, USA), Fitty Dent (Fittydent International, Austria), Corega (GlaxoSmithKline, UK) and Kukident (Reckitt Benckiser, Germany) were randomly distributed by the authors. The subjects were invited to use them for seven consecutive days according to each manufacturer's instructions.
The microbial plaque in both stages of the study was colored with the fluorescent revealer Plaque Test (Ivoclar Vivadent GmbH., Austria) and highlighted with a UV lamp. A sterile cotton swab soaked in revealer was used to cover the entire impression and polishing surfaces of the denture. The dentures were afterwards rinsed with water to ensure that the plaque identifier adhered only to areas with microbial plaque. The UV lamp was directed towards all of the surfaces of the dentures to highlight the areas loaded with plaque, which were consecutively photographed. For each patient, the area most loaded with microbial plaque of the dentures was noted (labial and buccal areas of the impression/ polished surface, and interdental spaces, respectively). Subjects were deliberately not informed concerning the areas showing highest fluorescence, in order to not influence the subsequent cleansing.
To qualitatively evaluate the microbial plaque on the dentures, it was collected with a sterile swab from the above-mentioned areas of the dentures. Labelled samples were transferred within two hours to the laboratory for bacterial and fungal media seeding. A loop of one microliter was used to seed the samples on each of three different growth media: blood agar (BA), bromothymol blue lactose agar (AABTL) and Sabouraud dextrose agar (SDA).
Results
Case 1
A 70-year-old bimaxillary, completely edentulous male patient with self-reported history of periodontitis, and wearing 15 years old PMMA complete dentures, addressed the Prosthetic Discipline to receive new dentures. The patient suffered from cardiovascular diseases controlled by chronic drug treatment and reported daily alcohol consumption and long-term smoking habits. The habits of wearing and cleansing the dentures consisted of wearing the dentures overnight, denture hygiene once a day with a manual toothbrush and soap, and the occasional use of denture disinfectant tablets and mouthwash for the oral cavity.
Objectively, the maxillary bearing area was covered by a fixed mucosa of uneven consistency and thickness, enlarged and hyperplastic in the frontal area, also exhibiting a tumor of benign appearance in the anterior third of the flat maxillary palatal vault. Its features were of the type of a 1 cm diameter epithelial papilloma without mobility on the underlying planes, bleeding episodes, or subjective symptomatology. Also, marked bone resorption was encountered at the edentulous ridges in the buccal areas, as well as atrophic maxillary tuberosities. The mandibular denture-bearing area consisted of a thin supporting mucosa classified in class III according to Lejoyeux [28], with a rather sharp asymmetric edentulous ridge, important bone resorption in the frontal area, and unfavorable high insertion of the labial and buccal notches.
Following revelation of the bacterial plaque on the impression surface of the maxillary denture, its accumulation was obvious in the oral slope of the labial flange, more on the left side of the denture impression surface. Important deposits of bacterial plaque on the level of the polished surface of the maxillary prosthesis were mainly identified in the interdental spaces, bilaterally. Comparatively, both the impression surface of the mandibular denture, and the polished one revealed a much lower quantity of microbial plaque than in the case of the maxillary denture. On the other hand, interdental areas on both left and right sides of the mandibular denture showed plaque deposits like those on the maxillary one.
The results after seeding on the culture media are presented in Table 1, together with the Petri dishes obtained in the first stage of the protocol, 24 hours after seeding and incubation at 37°C (Figure 1 a-c).
Table 1.
Composition of the microbial plaque – case no. 1.
Figure 1.
Petri plates with culture media at 24 hours after seeding: agar-blood (a), AABTL (b), Sabouraud dextrose (c).
Case 2
A 74-year-old female patient, with complete maxillary edentulism of mixed etiology (dental caries and periodontal disease), visited the Prosthetic Discipline wearing a 10-year-old PMMA complete denture, initially implantretained overdenture but muco-supported at the time of her presentation due to the loss of former implants. A Kennedy class II partial mandibular edentulism was treated using an eight-year-old implant-supported fixed partial denture. Pathological antecedents were arterial hypertension and diabetes mellitus, both being under permanent medication. Occasional consumption of alcohol and long-term smoking habits were also reported. Regarding denture wearing and hygiene control, continuous overnight use and twice a day cleansing of the complete denture by special denture brush, soap, and various cleansing tablets were recorded. For the oral cavity, the patient reported using a toothbrush and toothpaste, various mouthwashes, and a water flosser.
The denture bearing maxillary mucosa exhibited uneven consistency and variable resilience. Other peculiarities were the highvaulted palate and the low alveolar height in the zygomatico-alveolar crest areas, bilaterally.
Bacterial plaque accumulation on the impression surface of the maxillary denture was evident in the areas corresponding to the edentulous ridges, in the overdenture female attachment areas as well as at the level of the maxillary tuberosities. The polished surface of the denture showed significant plaque deposits on the occlusal surfaces of the molars and premolars on the right side. The buccal slope of the buccal flange on the left side showed significantly more bacterial plaque accumulation compared to the one on the right side. Consistent deposits of plaque were also detected on the occlusal surface of the denture, in the interdental spaces and on the cervical line of the artificial teeth.
The results after seeding on the culture media are shown in Table 2, Petri dishes from the first stage of the clinical protocol being presented in Figure 2 a-c, 24 hours after seeding and incubating them at 37°C.
Table 2.
Composition of the denture microbial plaque – case no. 2
.
Figure 2.
Petri dishes with agar-blood (a), AABTL (b), Sabouraud dextrose culture media (c) 24 hours after seeding.
Case 3
A 78-year-old female patient with Kennedy class I maxillary edentulism and subtotal mandibular edentulism, treated with a partial removable denture, respectively, a magnet retained full overdenture addressed for prosthetic treatment. Both dentures were four years old. The patient suffered from type II diabetes mellitus and autoimmune thyroiditis, both treated with appropriate medication. Rare alcohol consumption and chronic smoking habits were also recorded. Of the two removable dentures, the maxillary one was worn overnight while both were cleaned twice a day using the special prosthesis brush and soap, as well as various cleansing tablets. Regarding the oral cavity hygiene, mechanical cleansing with toothbrush and toothpaste, the use of various mouthwashes and a water flosser were registered. Clinical examination highlighted non-retentive tuberosities, pronounced transverse resorption of the posterior alveolar ridges, and a medium palatal torus in the anterior third of the palatal vault. For the mandible, a thin and tightly attached mucosa alongside an extremely resorbed ridge was found.
The impression surface of the maxillary partial denture showed significant bacterial plaque at both the posterior area of the saddles, and at their junction with the major connector. Increased plaque accumulation was found bilaterally at interdental and cervical areas. The mandibular overdenture showed bacterial plaque on the impression surface, especially on the magnetic keeper on 33 and at the interdental spaces. Table 3 presents the results after seeding the culture media. The Petri dishes from the first stage of the clinical protocol are shown in Figure 3 a-c.
Table 3.
Composition of the denture microbial plaque – case no. 3.
Figure 3.
Petri dishes with agar-blood (a), AABTL (b), and Sabouraud dextrose culture media (c) 24 hours after seeding.
Case 4
A 79-year-old male patient with bimaxillary total edentulism of carious etiology, rehabilitated only by a three-year-old maxillary implantsupported overdenture visited the Prosthetic Discipline for provision of new prostheses. No relevant general health issues were reported. Wearing of the overdenture overnight and its once-a-day mechanical cleansing, as well as using mouthwash for the hygiene of the oral cavity were reported. The clinical examination revealed a favorable maxillary denture bearing area, with minimal ridge resorption, weakly retentive tuberosities and a favorable attached mucosa in terms of thickness and resilience. The mandible denture bearing area showed similar conditions.
UV light highlighted important microbial plaque deposits on the impression surface of the maxillary denture, especially in the tuberosity areas, and in those corresponding to the implants. Regarding the polish surface of the denture, bacterial plaque was mainly found both on the occlusal surfaces, unilaterally and the interdental spaces, bilaterally. Table 4 shows the results of biological tests and Figure 4 a-c the macroscopic aspect of the Petri dishes from the first stage of the clinical protocol.
Table 4.
Composition of the denture microbial plaque – case no. 4.
Figure 4.
Petri dishes with agar-blood (a), AABTL (b), and Sabouraud dextrose culture media (c), 24 hours after seeding.
Discussion
The oral health of removable denture wearers affects in many ways the quality of life, [14]. the nutritional and psychosocial status [29,30]. and even the systemic health [31,32]. of the individuals, especially in the elderly population. Our investigation focused on the diversity of the denture microbiome, which is imprinted on the surface of the prosthesis [33]. and otherwise deeply correlated with the quality of the oral hygiene regime.
As dentures are unsterile and the complete microbiological representation of this environment is still difficult to assess due to its restricted classic culture techniques onto agar, [34]. scientific debates continue up to the present. In this regard, Hanady et al. described microorganisms such as Candida spp., Actinomyces spp., Lactobacillus spp., Streptococcus spp., and Veillonella spp., [35]. while O'Donnell et al. detected Actinobacteria and bacilli rather on dentures and denture-bearing mucosal areas [36]. An even wider microflora on denture surfaces was described by Coultwaite et al. who reported the preponderance of Streptococcus spp. (S. sanguinis, S. oralis, S. anginosus, S. salivarius), Staphylococcus spp. (S. aureus, S. epidermidis), Gram-positive rods (Actinomyces spp [A. israelii, A. naeslundii, A. odontolyticus], lactobacilli, Propionibacterium spp.), Veillonella spp., Gram-negative rods and yeasts [22]. In our research, frequent cultures of Streptococcus viridans were obtained in all subjects prior to the cleansing protocol, in line with other previous reports [37]. The result is concerning, since this germ is one of the most cited causes of aspiration pneumonia and endocarditis in denture wearers [38]. Another potential respiratory pathogen we isolated was Klebsiella pneumoniae, a Gramnegative bacillus, which, however, after following the hygiene protocol, was no longer detectable in subsequent cultures. Coronado et al [39]. detected it as the most frequent microbial species isolated on the acrylic resins and mentioned it as being responsible for pneumonia, primary liver abscesses, meningitis, and brain abscesses. The dentures investigated by us hosted coagulasenegative staphylococci, pathogens reputed for their capacity to cause various types of infections, ranging from mild skin infections to severe systemic diseases. One of the most significant virulence factors of these bacteria is their ability to form biofilms on solid surfaces by anchoring the planktonic cells and producing a protective layer of polymeric substances, thus explaining the alarming presence of these colonies on the denture surfaces in our study.
The final scene of the microbial hierarchy was populated by colonies of Actinomycetes spp. and Candida krusei. The coexistence of bacterial and fungal colonies on the same denture, as in our study, may suggest the synergistic behavior of the two microorganisms. The literature reports that some bacterial species produce molecules that kill or inhibit Candida spp., while others promote growth of the fungus [40]. The almost constant Candida spp. on acrylic resin dentures and their role in the etiology of denture stomatitis [7], and some systemic complications in senior patients, was unanimously documented [23,31,32]. The identification of nonalbicans subspecies in two of our cases supports the concern related to recent increase in the frequency of Candida krusei at global level, based on increased virulence and pathogenicity, with responses occurring most in critical patients, such as fungemia, endophthalmitis, arthritis, and endocarditis [41].
Another aim of the study was to map the sites of denture more prone to plaque accumulation. Thus, regardless of the type of removable denture we investigated, the denture plaque predominated in retentive areas, such as the connecting links between minor and major connector or base of the removable dentures, the female matrices for ball attachments, the magnetic keepers, and especially at interdental spaces. The last finding converges with the study of Merdes et al., who practically did not find any maxillary or mandibular denture without coloring of the interdental areas [42]. Greater plaque coverage on the impression surface of the dentures – almost twice as much as the polished, external surfaces – was also confirmed by Ikeia et al [20]. who explained it by its uneven surface morphology, allowing plaque retention and cleaning difficulty. It should be noted that the acrylic dentures evaluated by us presented the lowest amount of bacterial plaque on the buccal and lingual slopes of their polished surface, arguable by the permanent contact with the oro-maxillo-facial muscles at this level, which favors both maintenance and self-cleaning in these areas.
However, the observations of our study derived from the analysis of limited cases that restricts the results' generalizability. The report does not provide quantitative data on the amount of microbial plaque present, while other limitations consist of the lack of a control group, the potential biases in plaque detection and sampling, or the subjective nature of the plaque quantification method. Even so, starting from the almost absent reports on this topic in Romania, important recommendations in clinical practice for both dentists and denture wearers can be derived from this investigation. Thus, almost complete reduction of denture bacterial plaque can be achieved if both mechanical and chemical hygiene of the dentures (regardless of the type of cleansing product used) is properly and constantly carried out.
Conclusions
Despite the narrow variability revealed through our investigation, the denture microbiome of patients wearing removable PMMA prostheses can harbor germs with high pathogenic potential such as streptococci (S. viridans), coagulase-negative staphylococci, Actinomycetes spp., Klebsiella spp. (K. pneumoniae) as well as yeasts that belong to the genus Candida (C. krusei). Microbial plaque is found in considerable quantity, especially in the retentive areas and the mucosal surfaces of the acrylic dentures, regardless of their type (conventional complete dentures, teeth supported overdentures, implant supported overdentures, partial removable dentures, etc.), but an effective biocontrol can be ensured by following a rigorous hygiene technique by the patients.
Author Contributions
Conceptualization, LI, AI and OEA; methodology, AMCȚ and MI; formal analysis, BD, OEA and AMCȚ; resources, MI, MP and BD; writing—original draft preparation, BD, OEA and AMCȚ; writing—review and editing, LI, AI and OEA; visualization, MP and MI; supervision, LI. OEA and AI have equally contributed as the first author. All authors read and approved the final version of the manuscript.
Funding
None to declare.
Conflicts of Interest
All authors—none to declare.
References
- McGarry, T.J.; Nimmo, A.; Skiba, J.F.; Ahlstrom, R.H.; Smith, C.R.; Koumjian, J.H. Classification system for complete edentulism. J Prosthodont. 1999, 8, 27–39. [Google Scholar] [CrossRef]
- Herzberg, I.; Schimmel, M.; Müller, F.; Biffar, R. Edentulism as part of the general health problems of older adults. Int Dent J. 2010, 60, 143–155. [Google Scholar] [CrossRef]
- World Health Organization. 2022. Available online: https://cdn.who.int/media/docs/default-source/country-profiles/oral-health/oral-health-rou-2022-country-profile.pdf?sfvrsn=6b74cbdc_9&download=true (accessed on 5 February 2024).
- Budală, D.G.; Baciu, E.R.; Virvescu, D.I.; et al. Quality of life of complete denture wearers—a comparative study between conventional dentures and acrylic dentures with vitamin B12 incorporated. Medicina. 2021, 57, 820. [Google Scholar] [CrossRef] [PubMed]
- Saeed, F.; Muhammad, N.; Khan, A.S.; et al. Prosthodontics dental materials: from conventional to unconventional. Mater Sci Eng C. 2020, 106, 110167. [Google Scholar] [CrossRef] [PubMed]
- Andrei, O.; Mărgărit, R.; Tanasescu, L.; Dăguci, L.; Dăguci, C. Prosthetic rehabilitation of complete edentulous patients with morphological changes induced by age and old illfitted dentures. Rom J Morphol Embryol. 2016, 57, 8614. [Google Scholar]
- McReynolds, D.E.; Moorthy, A.; Moneley, J.O.C.; Jabra-Rizk, M.A.; Sultan, A.S. Denture stomatitis-an interdisciplinary clinical review. J Prosthodont. 2023, 32, 560–570. [Google Scholar] [CrossRef]
- Gray, D.; Patel, J. Implant-supported overdentures: part 1. Br Dent J. 2021, 231, 94–100. [Google Scholar] [CrossRef]
- Silva, T.S.O.; Freitas, A.R.; Pinheiro, M.L.L.; Nascimento, C.D.; Watanabe, E.; Albuquerque, R.F. Oral biofilm formation on different materials for dental implants. J Vis Exp. 2018, 136, e57756. [Google Scholar] [CrossRef]
- Kusama, T.; Aida, J.; Yamamoto, T.; Kondo, K.; Osaka, K. Infrequent denture cleaning increased the risk of pneumonia among community-dwelling older adults: a population-based cross-sectional study. Sci Rep. 2019, 9, 13734. [Google Scholar] [CrossRef]
- Thu, K.M.; Yeung, A.W.K.; Samaranayake, L.; Lam, W.Y.H. Denture plaque biofilm visual assessment methods: a systematic review. Int Dent J. 2024, 74, 1–14. [Google Scholar] [CrossRef] [PubMed]
- Konstantopoulou, K.; Kossioni, A.E. Association between oral hygiene information sources and daily dental and denture care practices in urban community-dwelling older adults. J Clin Med. 2023, 12, 2881. [Google Scholar] [CrossRef] [PubMed]
- Feine, J.S.; Carlsson, G.E.; Awad, M.A.; et al. The McGill consensus statement on overdentures. Gerodontology 2002, 19, 3–4. [Google Scholar] [CrossRef] [PubMed]
- Awad MA, Rashid F, Feine JS, Overdenture Effectiveness Study Team Consortium. The effect of mandibular 2-implant overdentures on oral healthrelated quality of life: an international multicentre study. Clin Oral Implants Res. 2014, 25, 46–51. [Google Scholar] [CrossRef]
- Ardelean, L.C.; Rusu, L.C.; Tigmeanu, C.V.; Negrutiu, L.; Pop, D.M. Advances in dentures: novel polymeric materials and manufacturing technologies. IntechOpen 2023. [Google Scholar] [CrossRef]
- Soygun, K.; Bolayir, G.; Boztug, A. Mechanical and thermal properties of polyamide versus reinforced PMMA denture base materials. J Adv Prosthodont. 2013, 5, 153–160. [Google Scholar] [CrossRef] [PubMed]
- Cazzaniga, G.; Ottobelli, M.; Ionescu, A.; et al. Surface properties of resin-based composite materials and biofilm formation: a review of the current literature. Am J Dent. 2015, 28, 311–320. [Google Scholar]
- Alqutaibi, A.Y.; Baik, A.; Almuzaini, S.A.; et al. Polymeric denture base materials: a review. Polymers. 2023, 15, 3258. [Google Scholar] [CrossRef]
- Chladek, G.; Basa, K.; Mertas, A.; et al. Effect of storage in distilled water for three months on the antimicrobial properties of poly (methyl methacrylate) denture base material doped with inorganic filler. Materials. 2016, 9, 328. [Google Scholar] [CrossRef]
- Ikeya, K.; Iwasa, F.; Inoue, Y.; et al. Inhibition of denture plaque deposition on complete dentures by 2methacryloyloxyethyl phosphorylcholine polymer coating: a clinical study. J Prosthet Dent. 2018, 119, 67–74. [Google Scholar] [CrossRef]
- O'Donnell, L.E.; Robertson, D.; Nile, C.J.; et al. The oral microbiome of denture wearers is influenced by levels of natural dentition. PLoS One 2015, 10, e0137717. [Google Scholar] [CrossRef]
- Coulthwaite, L.; Verran, J. Potential pathogenic aspects of denture plaque. Br J Biomed Sci. 2007, 64, 180–189. [Google Scholar] [CrossRef]
- Fukai, K.; Ogawa, H.; Hescot, P. Oral health for healthy longevity in an ageing society: maintaining momentum and moving forward. Int Dent J. 2017, 67 (Suppl. S2), 3–6. [Google Scholar] [CrossRef]
- Sumi, Y.; Hideaki, O.; Yoshiaki, K.; Yasuaki, H.; Yuuji, M.H. . High correlation between the bacterial species in denture plaque and pharyngeal microflora. Gerodontology. 2004, 20, 84–87. [Google Scholar] [CrossRef] [PubMed]
- D’Ambrosio, F.; Santella, B.; Di Palo, M.P.; Giordano, F.; Lo Giudice, R. Characterization of the oral microbiome in wearers of fixed and removable implant or non-implantsupported prostheses in healthy and pathological oral conditions: a narrative review. Microorganisms. 2023, 11, 1041. [Google Scholar] [CrossRef]
- Müller, F.; Shimazaki, Y.; Kahabuka, F.; Schimmel, M. Oral health for an ageing population: the importance of a natural dentition in older adults. Int Dent J. 2017, 67 (Suppl. S2), 7–13. [Google Scholar] [CrossRef]
- Carta, M.G.; Cossu, G.; Pintus, E.; et al. Moderate exercise improves cognitive function in healthy elderly people: results of a randomized controlled trial. Clin Pract Epidemiol Ment Health. 2021, 17, 75. [Google Scholar] [CrossRef]
- Lejoyeux, J. Traitement de l‘edentation totale; Maloine: Paris, France, 1976. [Google Scholar]
- Jar, H.A.; Alabbas, B.M.; Khormi, A.A.; et al. The effect of dentures on oral health and the quality of life. Int J Community Med Public Health. 2023, 10, 5067–5071. [Google Scholar] [CrossRef]
- Moynihan, P.; Varghese, R. Impact of wearing dentures on dietary intake, nutritional status, and eating: a systematic review. JDR Clin Trans Res. 2022, 7, 334–351. [Google Scholar] [CrossRef] [PubMed]
- Preshaw, P.M.; Walls, A.W.G.; Jakubovics, N.S.; Moynihan, P.J.; Jepson, N.J.A.; Loewy, Z. Association of removable partial denture use with oral and systemic health. J Dent. 2011, 39, 711–719. [Google Scholar] [CrossRef]
- Le Bars, P.; Kouadio, A.A.; N’goran, J.K.; Badran, Z.; Soueidan, A. Relationship between removable prosthesis and some systemic disorders. J Indian Prosthodont Soc. 2015, 15, 292. [Google Scholar] [CrossRef]
- Delaney, C.; O'Donnell, L.E.; Kean, R.; et al. Interkingdom interactions on the denture surface: implications for oral hygiene. Biofilm. 2019, 1, 100002. [Google Scholar] [CrossRef]
- Redfern, J.; Tosheva, L.; Malic, S.; Butcher, M.; Ramage, G.; Verran, J. The denture microbiome in health and disease: an exploration of a unique community. Lett Appl Microbiol. 2022, 75, 195–209. [Google Scholar] [CrossRef]
- Lamfon, H.; Al-Karaawi, Z.; McCullough, M.; Porter, S.R.; Pratten, J. Composition of in vitro denture plaque biofilms and susceptibility to antifungals. FEMS Microbiol Lett. 2005, 242, 345–351. [Google Scholar] [CrossRef]
- O'Donnell, L.E.; Robertson, D.; Nile, C.J.; et al. The oral microbiome of denture wearers is influenced by levels of natural dentition. PLoS One. 2015, 10, e0137717. [Google Scholar] [CrossRef]
- Nair, V.V.; Karibasappa, G.N.; Dodamani, A.; Prashanth, V.K. Microbial contamination of removable dental prosthesis at different intervals of usage: an in vitro study. J Indian Prosthodont Soc. 2016, 16, 346–351. [Google Scholar] [CrossRef]
- Andonissamy, L.; Karthigeyan, S.; Ali, S.A.; Felix, J.W. Effect of chemical denture disinfectants and tree extracts on biofilm-forming Staphylococcus aureus and viridans Streptococcus species isolated from complete denture. J Contemp Dent Pract. 2019, 20, 1307–1314. [Google Scholar] [CrossRef] [PubMed]
- Coronado, M.L.P.; Tinoco, C.V.C.; Méndez, M.R.; et al. Identificación bacteriana en superficies de resina acrílica. Rev ADM. 2017, 74, 40–45. [Google Scholar]
- Xu, H.; Jenkinson, H.F.; Dongari-Bagtzoglou, A. Innocent until proven guilty: mechanisms and roles of Streptococcus-Candida interactions in oral health and disease. Mol Oral Microbiol. 2014, 29, 99–116. [Google Scholar] [CrossRef]
- Samaranayake, Y.H.; Samaranayake, L.P. Candida krusei: biology, epidemiology, pathogenicity, and clinical manifestations of an emerging pathogen. J Med Microbiol. 1994, 41, 295–310. [Google Scholar] [CrossRef]
- Merdes, L.; Soueidan, A.; Le Bars, P.; Tabbi-Aneni, N. Mise en évidence des sites préférentiels d'accumulation de la plaque microbienne prothétique par coloration des extrados des prothèses amovibles complètes. Odontostomatol Trop. 2009, 32, 33–41. [Google Scholar] [PubMed]
© GERMS 2024.